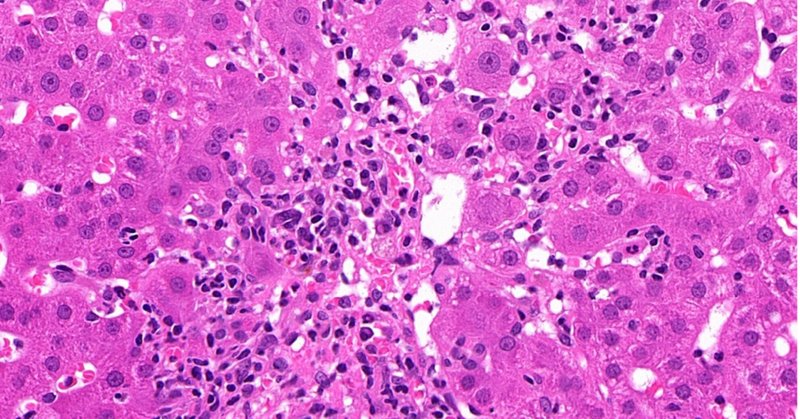
Tweet card summary image

Catriona Mckenzie
@CatrionaMckenz5
Followers
2K
Following
3K
Media
64
Statuses
899
GI, liver and skin pathologist RPAH Clinical Prof. University Sydney. Chair RCPA Academic Committee. President elect Australasian IAP. Marathon runner.
Sydney, New South Wales
Joined August 2019
Dr. @GuptaRuta presents the Head & Neck CLEAR project on ENE in HNSCC - remember, it all starts with a good gross! @NASHNPath @HeadNeckPathol @TheUSCAP #USCAP2025 #ENTPath
0
28
66
Calling all Gastrointestinal Pathology enthusiasts. Registration is now open. Don’t miss out. https://t.co/i2QhpqFuD0
#GIPath #PathTwitter #PathX #pathology #pathologist
2
3
8
Brilliant talk by Dr. Touraj Taheri. Thanks @IAP_AUS for organising and supporting ongoing education. Highlight of my day. #Pathology #entpath
1
1
5
2nd RCPA summer school - why choose pathology? Fantastic to see so many keen and interested medical students @PathologyRCPA @KMirza @Path_SIG @RCPath @RCPAPresident
1
4
11
Really looking forward to generating some discussion on advancing women in pathology leadership @TheUSCAP #USCAP2025 with our interactive and topical course
0
2
11
Looking forward to doing an IM course on my favourite topic in my favourite organ @TheUSCAP in Boston #USCAP2025 - I have a fantastic collection of cases to share on this important entity
0
5
14
Good news! Gnomes’🔺paper on ⚡️Acute Hepatitis🔬has received over 1,800 views since publication! Read it here https://t.co/MOhccQjSCN
#ViewsMilestone @EASLnews @ESP_Pathology @AASLDtweets @LiverPath_HPHS @UKLiverPath @my_ueg #PathTwitter #liverTwitter @DavidKleiner12
onlinelibrary.wiley.com
This overview provides an insight into the contemporary role of biopsies (as well as explant and autopsy material) in diagnosing acute liver disease. It outlines up-to-date clinical definitions of...
1
5
17
Excellent sessions at the annual Australian Gastrointestinal Pathology Society Meeting followed by dinner at The Boatshed. #gitpathology @AusGIPath
0
4
7
Always great to catch up with GI colleagues! Look forward to Sydney 2025
0
4
8
Should be a great meeting @priyanthi_k2017 @RAStandish
SAVE THE DATE for AGPS 30 October - 1 November 2025 in Sydney with international faculty “Top to Tail - a Gastrointestinal Odyssey”
1
0
7
Save the date for the IAP 2025 🤩 To meet the needs of the growing number of sub specialised pathologists we have new short courses this year. Also boot camps for our trainees! @IAP_AUS @FionaMacPath @priyanthi_k2017
0
4
7
Friday 14 June 2024 is my last day @PathologyRCPA after 18.5 amazing years . Thx to the incredible Fellowship , you are all inspirational! It has been my privilege & honour. #TeamHaem & #ForensicFamilyForever #MedicineisPathology 🩷
5
3
34
Congratulations to our Deputy Editor-In-Chief Prof Wendy Cooper, who was awarded the Distinguished Pathologist medal at the 48th Annual Scientific Meeting of @IAP_AUS over the weekend, recognising her outstanding contribution to the discipline of pathology. #PathTwitter
1
4
10
Great to be part of DEI discussion @IAP_AUS and to hear from our panel including distinguished pathologist @WendyCoope17790 and @LiangRhea from surgery. To be continued!
0
1
11
The #DiversityAndInclusion at @IAP_AUS starts with two pathology legends @CatrionaMckenz5 and @WendyCoope17790 'Can snow ploughing be sexist?' Short answer- yes, because most snowplough drivers are men, but when women are included, accidents *halve*.
2
2
9